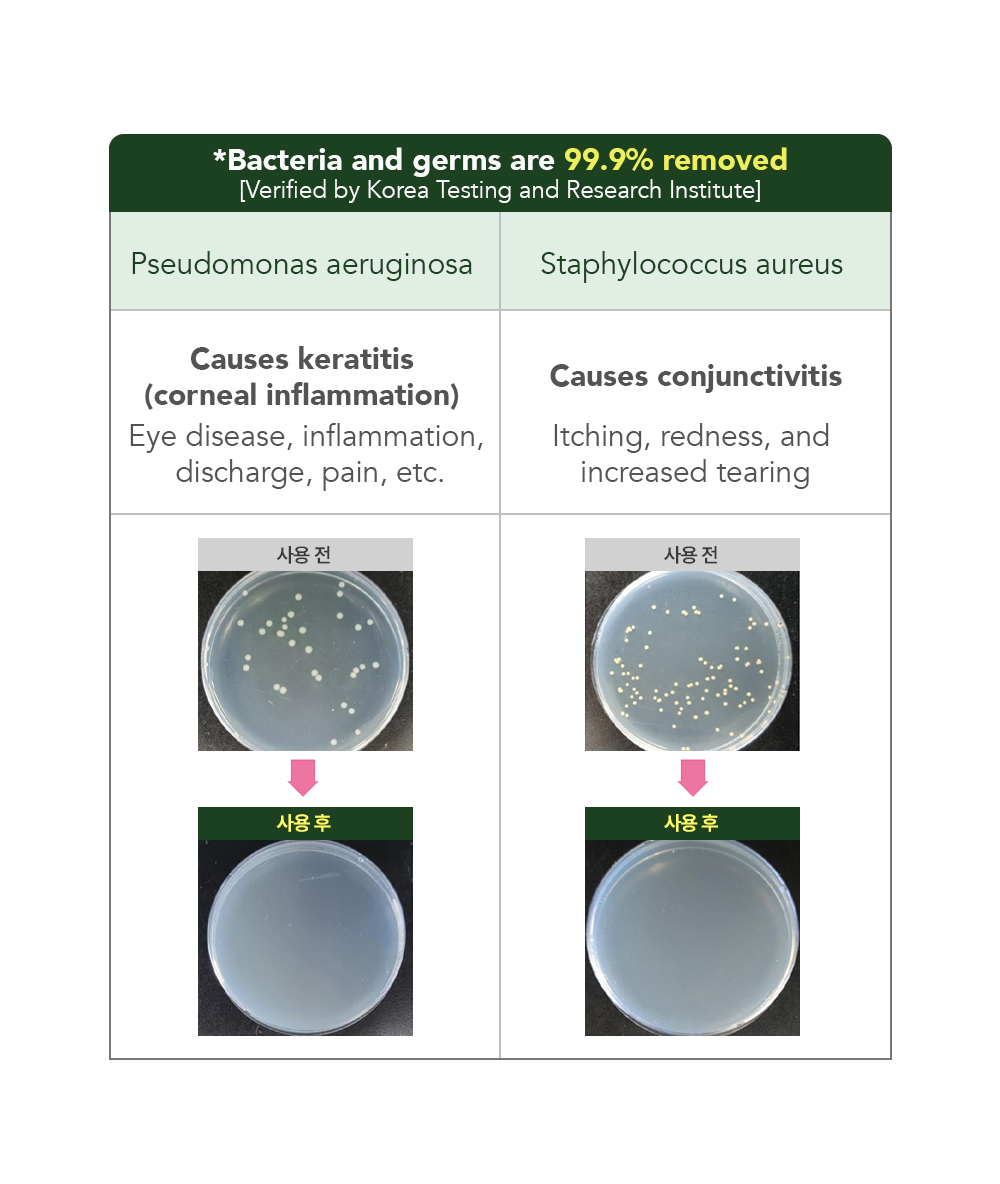

Snowy-Eye Cleaner
You may also like
Reviews
This cat… has been picky about litter since they were a kitten. If they didn’t like the litter, they would hold in their poop for days… 😅
When I first got tofu litter and a cheap litter from Daiso, my cat refused to go for days. In a panic, I bought expensive bentonite litter through a secondhand app, and only then did they finally relieve themselves after holding it in.
After they grew up, I tried tofu litter again, but they wouldn’t even step on it. However, bentonite litter is so heavy, I felt like my back was breaking. I decided to give Duit Tofu Sand a try as a last resort, specifically choosing it because it’s one of the finest tofu litters available.
!!! And they’re using it !!!!!
I was ready to pass it on to another tofu litter household if it didn’t work out, but they’re actually using it! While they may not be 100% thrilled, it seems to be more of a “fine, I’ll use it” attitude, which is a win in my book.
Pros for Humans:
- 21L at 7kg—I’m emotional just thinking about how lightweight this is compared to bentonite.
- My back and arms are saved.
Cat’s Feedback:
- While their paws sink into the litter a bit more than bentonite, they don’t seem too bothered by it.
I’m so thankful… truly. This product is a game-changer for us. I’m going to subscribe immediately!
For reference, based on their litter box size, 2 full bags plus 1/2 to 2/3 of another bag seems to be the right amount.
Thank you, Duit, for saving my back and making my picky cat’s litter tolerable! 🙏
-박정****
- McCrea Le Compte
The moment I poured the litter for a full change, I just knew it—"My little one is going to love this~~ ^^"
Usually, when I change litter, my cat spends a long time exploring before stepping in, but with Poo Poo Sand, they went in right away as if it were their usual litter. They did their business and walked out casually. A total success!
The litter is incredibly soft and has a slightly moist feel, with very uniform particles. Honestly, I like it even better than some of the pricier litters I’ve used.
Since the litter is fine and slightly moist, there’s absolutely no dust, and the clumps formed perfectly—not too soft, not too hard.
This is a definite repurchase for me! ♡♡